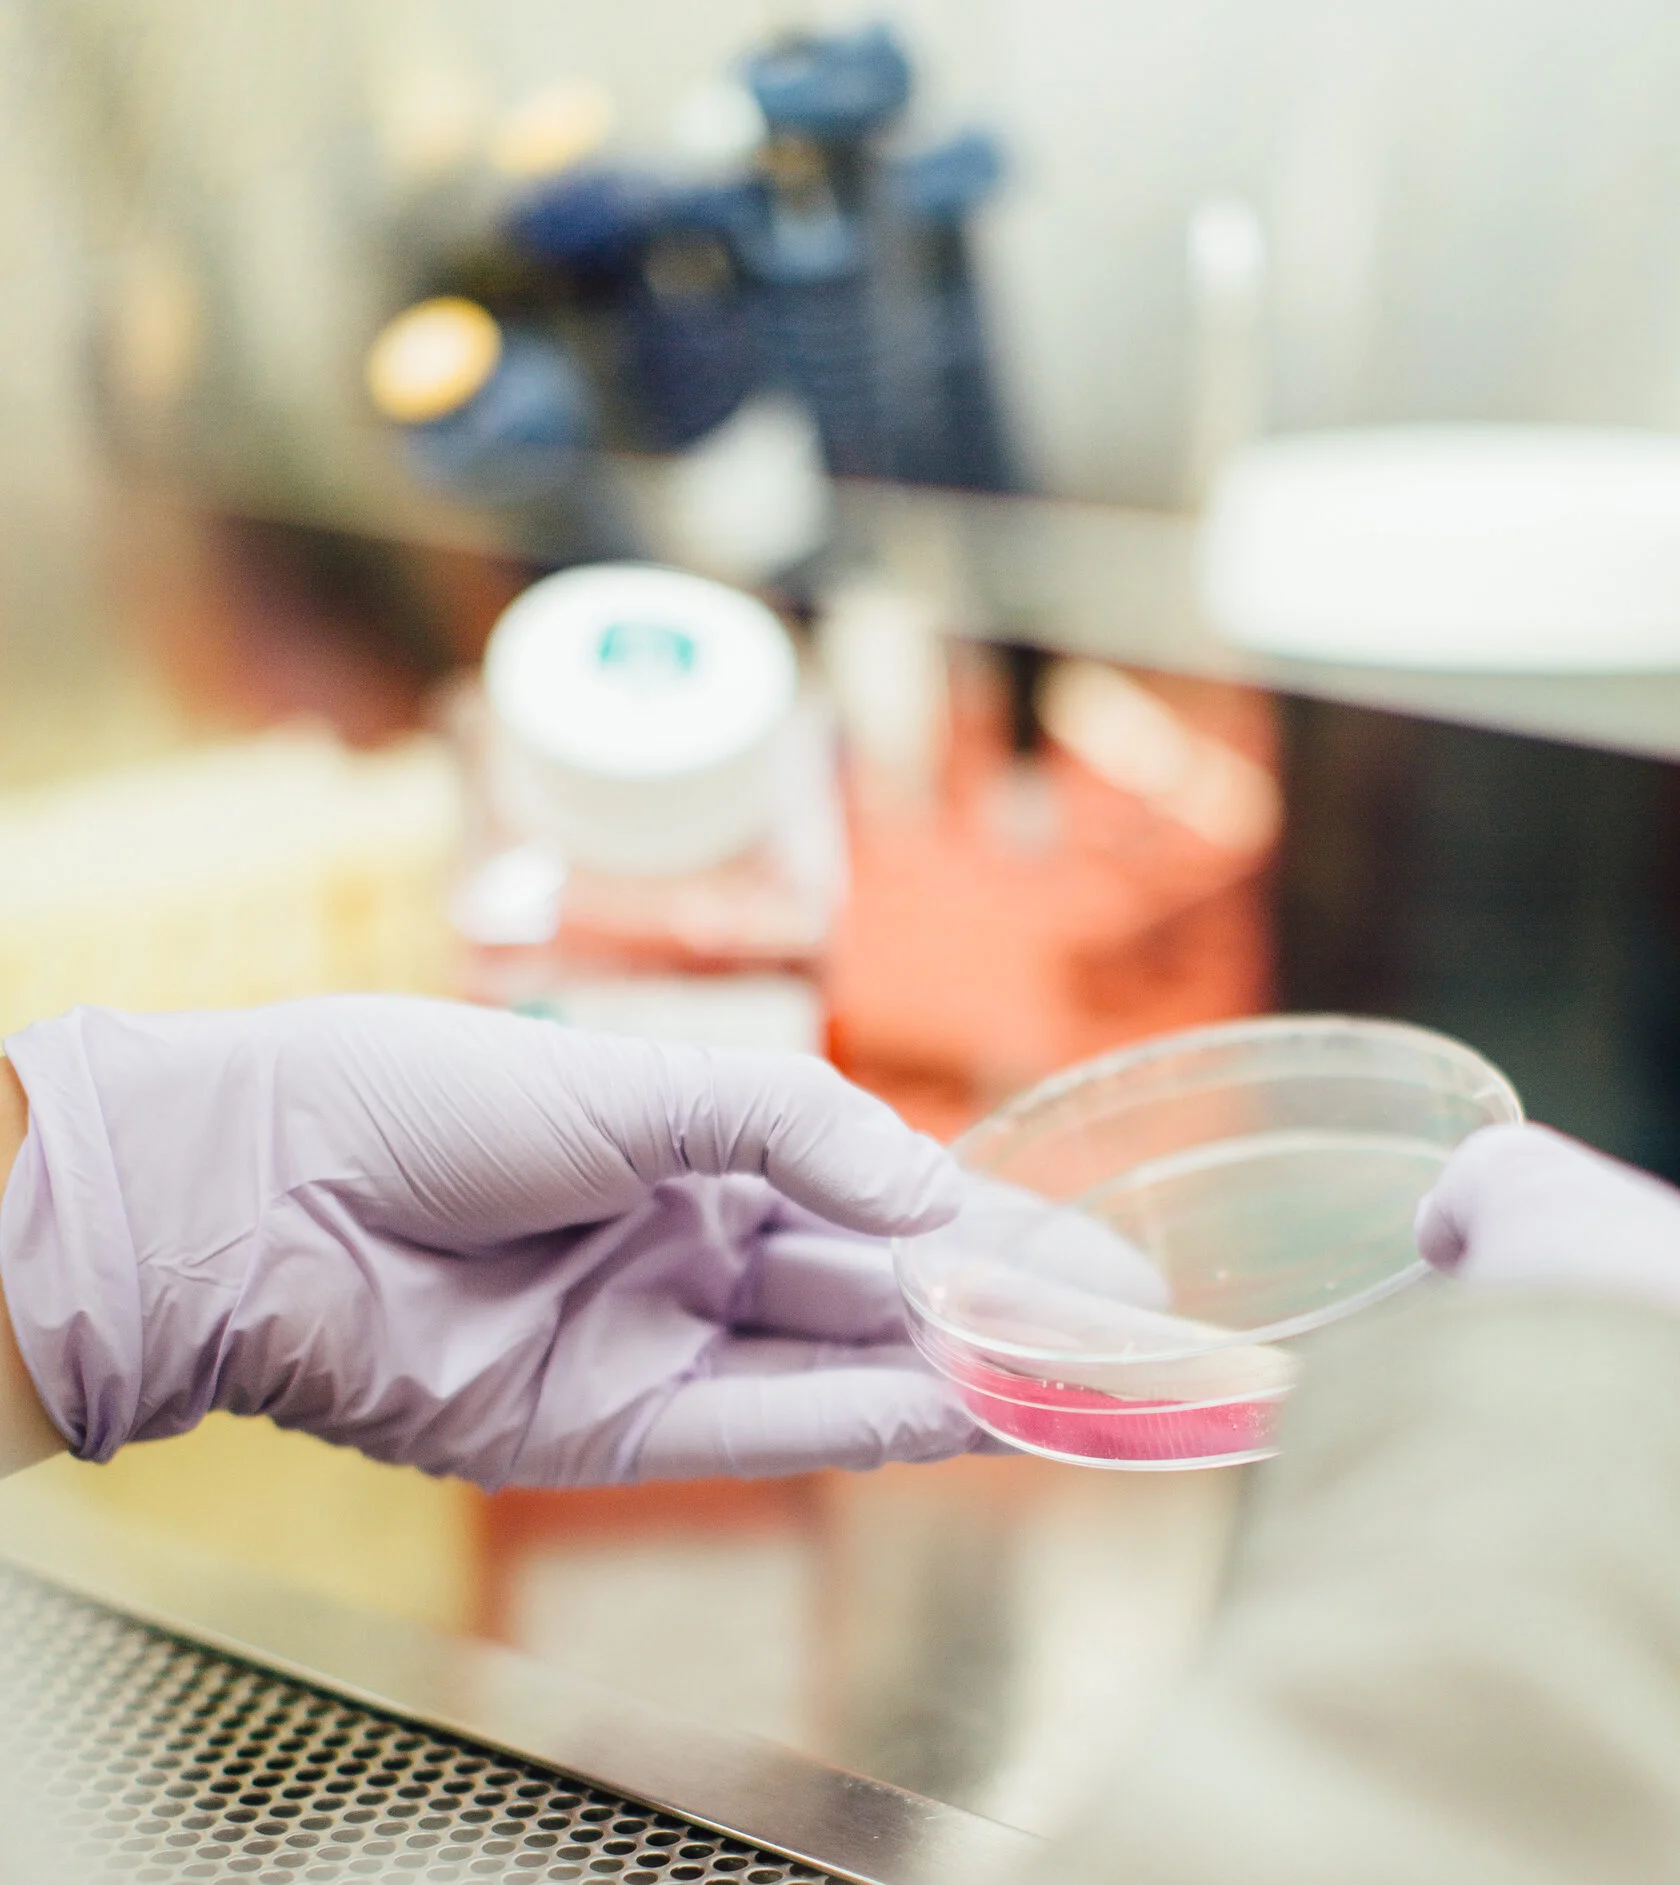
problems.jpg

About us
CHEMEX is an Armenian research company.
It is aimed at developing long-term and mutually beneficial relationships with drug manufacturers.
An integrated approach to the implementation of pharmaceutical development.
Activities of CHEMEX
-
Pharmaceutical development of API and FPP
Draft normative document
Pharmaceutical development report -
Technology Transfer of API and FPP
Technology Transfer Report
-
Equipment selection
URS and offer for the selected equipment

Pharmaceutical development goals
Quality cannot be tested in a drug, quality must be built into the pharmaceutical development.
- Сreation of a medicinal product of the required quality
- Substantiation of the process of its production
- Subsequent production of products with specified functional characteristics without deviations and the risk of complaints
Stages of pharmaceutical
development
- Preliminary exploratory studies, development of API production technology
- Preliminary exploratory studies, development of the composition and production technology of FPP
- Development and validation of analysis methods
- Dissolution kinetics research
- Standardization of API and excipients
- Stability study
Problems that pharmaceutical
companies face today
Time-to-market for a drug plays a critical role in the development of pharmaceutical companies
The need to search for and develop new drugs to expand the portfolio of manufactured drugs
High complexity and duration of pharmaceutical development
Lack of resources for research and pharmaceutical development
High competition in the drug market
Our task is to carry out pharmaceutical development of a drug and lay the foundation for the quality of future products for subsequent stable production
Technological possibilities
in dosage forms

Tablets

Hard gelatin capsules

Powders and granules

Tablets used in oral cavity
for sucking, chewable orally dispersible, etc.

Film-coated tablets

Modified release tablets
enteric, with prolonged release, etc.

Lyophilizates
Our advantages
-
Professional
Qualified specialists with extensive experience in the field of pharmaceutical development and quality assessment, production and quality control of medicines
-
Modern
Modern equipment that allows solving a wide range of analytical and technological problems
-
Helpful
Assistance in the formation of the Registration Dossier in terms of production and analytics, responses to requests for drug registration
-
Affordable
Reasonable deadlines and budget for projects of any complexity
